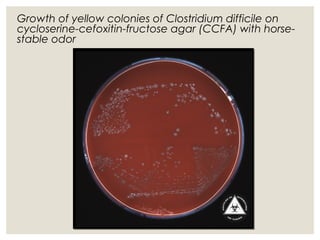
Growth of yellow colonies of Clostridium difficile on
cycloserine-cefoxitin-fructose agar (CCFA) with horse-
stable odor

This document provides an overview of anaerobic infections. It defines anaerobes and discusses their role as commensal flora. It describes the diseases caused by anaerobic bacteria and the sites they commonly infect. The document outlines the pathogenesis of anaerobic infections and their increasing incidence. It discusses the importance of laboratory diagnosis and describes methods for specimen collection, transport, culture, and identification of anaerobic bacteria.